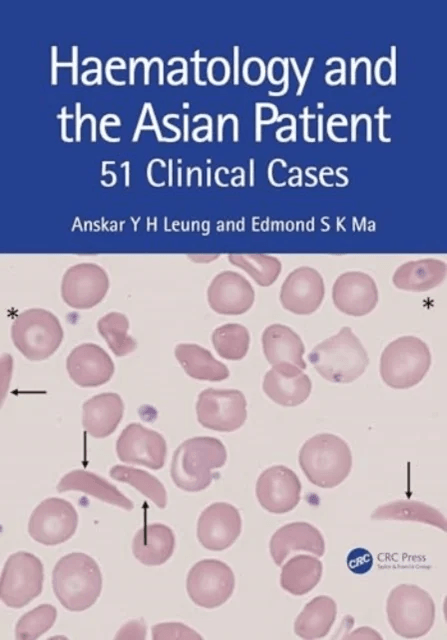
Haematology and the Asian Patient av Anskar Y.H. (University of Hong Kong) Leung, Edmond S K Ma

Haematology and the Asian Patient av Anskar Y.H. (University of Hong Kong) Leung, Edmond S K Ma
Sammenlign priser fra 869 kr til 869 kr. •Tilgjengelig hos 1 nettbutikk.
Pris nå: 869 kr
Til prishistorikk
Prishistorikk og utvikling
Sammenlign priser fra ulike nettbutikker, og se prisutviklingen over tid.
Få varsel ved prisfall
Vi overvåker prisen på dette produktet og sender deg varsel når den faller. Helt gratis og uten spam.
Om produktet
Produktnavn
Haematology and the Asian Patient av Anskar Y.H. (University of Hong Kong) Leung, Edmond S K Ma
Produkttype